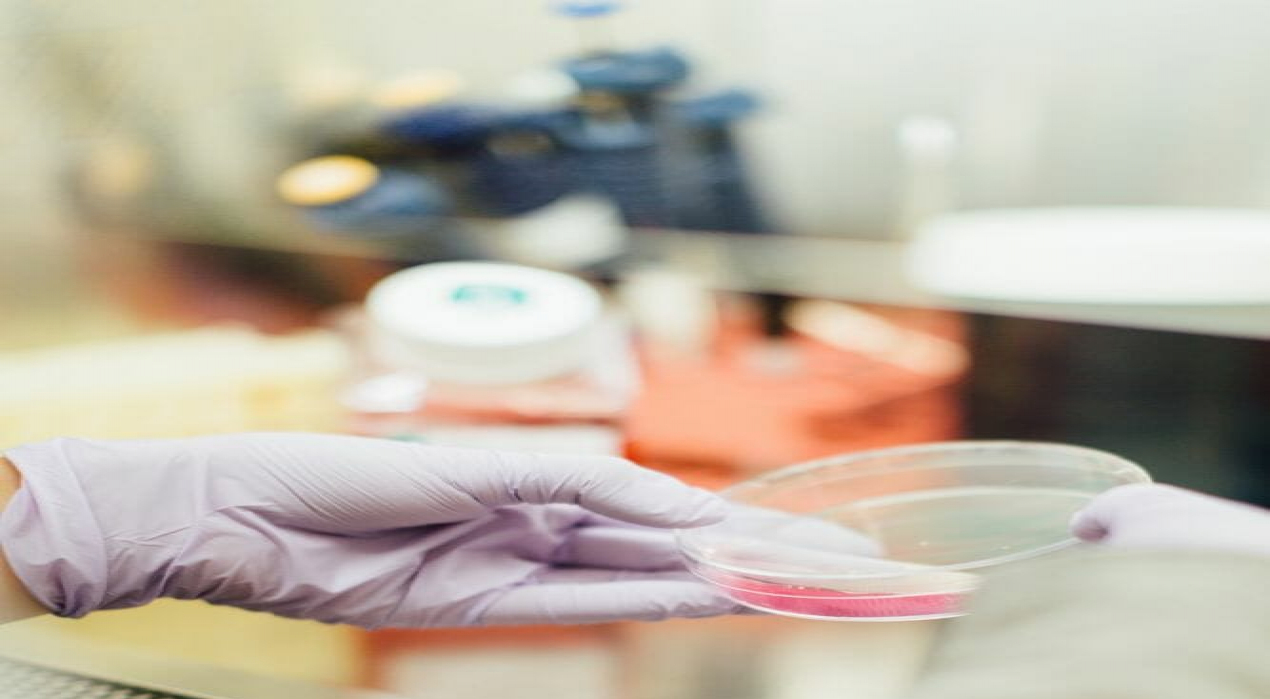

Uma revolução para a humanidade nos últimos séculos. Cientistas israelenses afirmam que estão no caminho para uma cura para o câncer. A pequena equipe de cientistas israelenses está dizendo ao mundo que eles terão a primeira “cura completa” para o câncer dentro de um ano, informou o Jerusalem.
Eles afirmam que o medicamento será breve, barato e eficaz e não terá nenhum ou efeitos colaterais mínimos.
Caso o método dê certo, será uma revolução para a humanidade nos últimos séculos.
“Acreditamos que ofereceremos em um ano uma cura completa para o câncer”, disse Dan Aridor , presidente do conselho da Accelerated Evolution Biotechnologies Ltd. ( AEBi), empresa fundada em 2000 na incubadora ITEKno Kiryat Weizmann Science Park. em Ness Ziona, Israel, ao norte doInstituto Weizmann de Ciência em Rehovot, Israel. Uma empresa biofarmacêutica de estágio de desenvolvimento engajada na descoberta e desenvolvimento de peptídeos terapêuticos, a AEBi desenvolveu a plataforma SoAP, uma tecnologia combinatória de plataforma de triagem de biologia, que fornece indicações funcionais – agonista, antagonista, inibidor, etc. – a alvos muito difíceis.
O Jerusalem Post informou que o medicamento contra o câncer é baseado na chamada tecnologia Soap da AEBi, que pertence ao grupo de tecnologias de exibição de fagos. Com isso, “os cientistas introduzem o DNA codificador de uma proteína, como um anticorpo, em um bacteriófago – um vírus que infecta bactérias. A proteína é então exibida na superfície do fago. Os pesquisadores podem usar esses fagos exibindo proteínas para rastrear interações com outras proteínas, seqüências de DNA e pequenas moléculas ”.
Uma equipe de cientistas ganhou o Prêmio Nobel no ano passado por seu trabalho sobre a exibição de fagos na evolução dirigida de novas proteínas – em particular, para a produção de anticorpos terapêuticos, relatou o The Jerusalem Post . “AEBi está fazendo algo semelhante, mas com peptídeos, compostos de dois ou mais aminoácidos ligados em uma cadeia.” Segundo Morad, peptídeos têm várias vantagens sobre os anticorpos, incluindo que eles são menores, mais baratos e mais fáceis de produzir e regular.
De acordo com um artigo no Science Direct da Elsevier, a terapêutica peptídica desempenhou um papel notável na medicina desde o advento da terapia com insulina na década de 1920. “Mais de 60 drogas peptídicas são aprovadas nos Estados Unidos e em outros mercados importantes, e os peptídeos continuam a entrar em desenvolvimento clínico em um ritmo constante”, afirma o artigo.
A Agência Internacional de Pesquisa sobre o Câncer (IARC) da Organização Mundial da Saúde (OMS) estima que a carga global do câncer tenha aumentado para 18,1 milhões de novos casos e 9,6 milhões de mortes em 2018. A IARC informa 1 em cada 5 homens e 1 em 6 mulheres em todo o mundo desenvolvem câncer durante sua vida, e 1 em cada 8 homens e 1 em 11 mulheres morrem da doença. Além disso, a cada sexta morte no mundo é devido ao câncer, tornando-se a segunda principal causa de morte, perdendo apenas para a doença cardiovascular.
Redação com Jerusalem Post
Leia mais notícias sobre o mundo jurídico no Portal Juristas. Adquira seu certificado digital E-CPF ou E-CNPJ com a Juristas. Entre em contato através do WhatsApp (83) 9 93826000